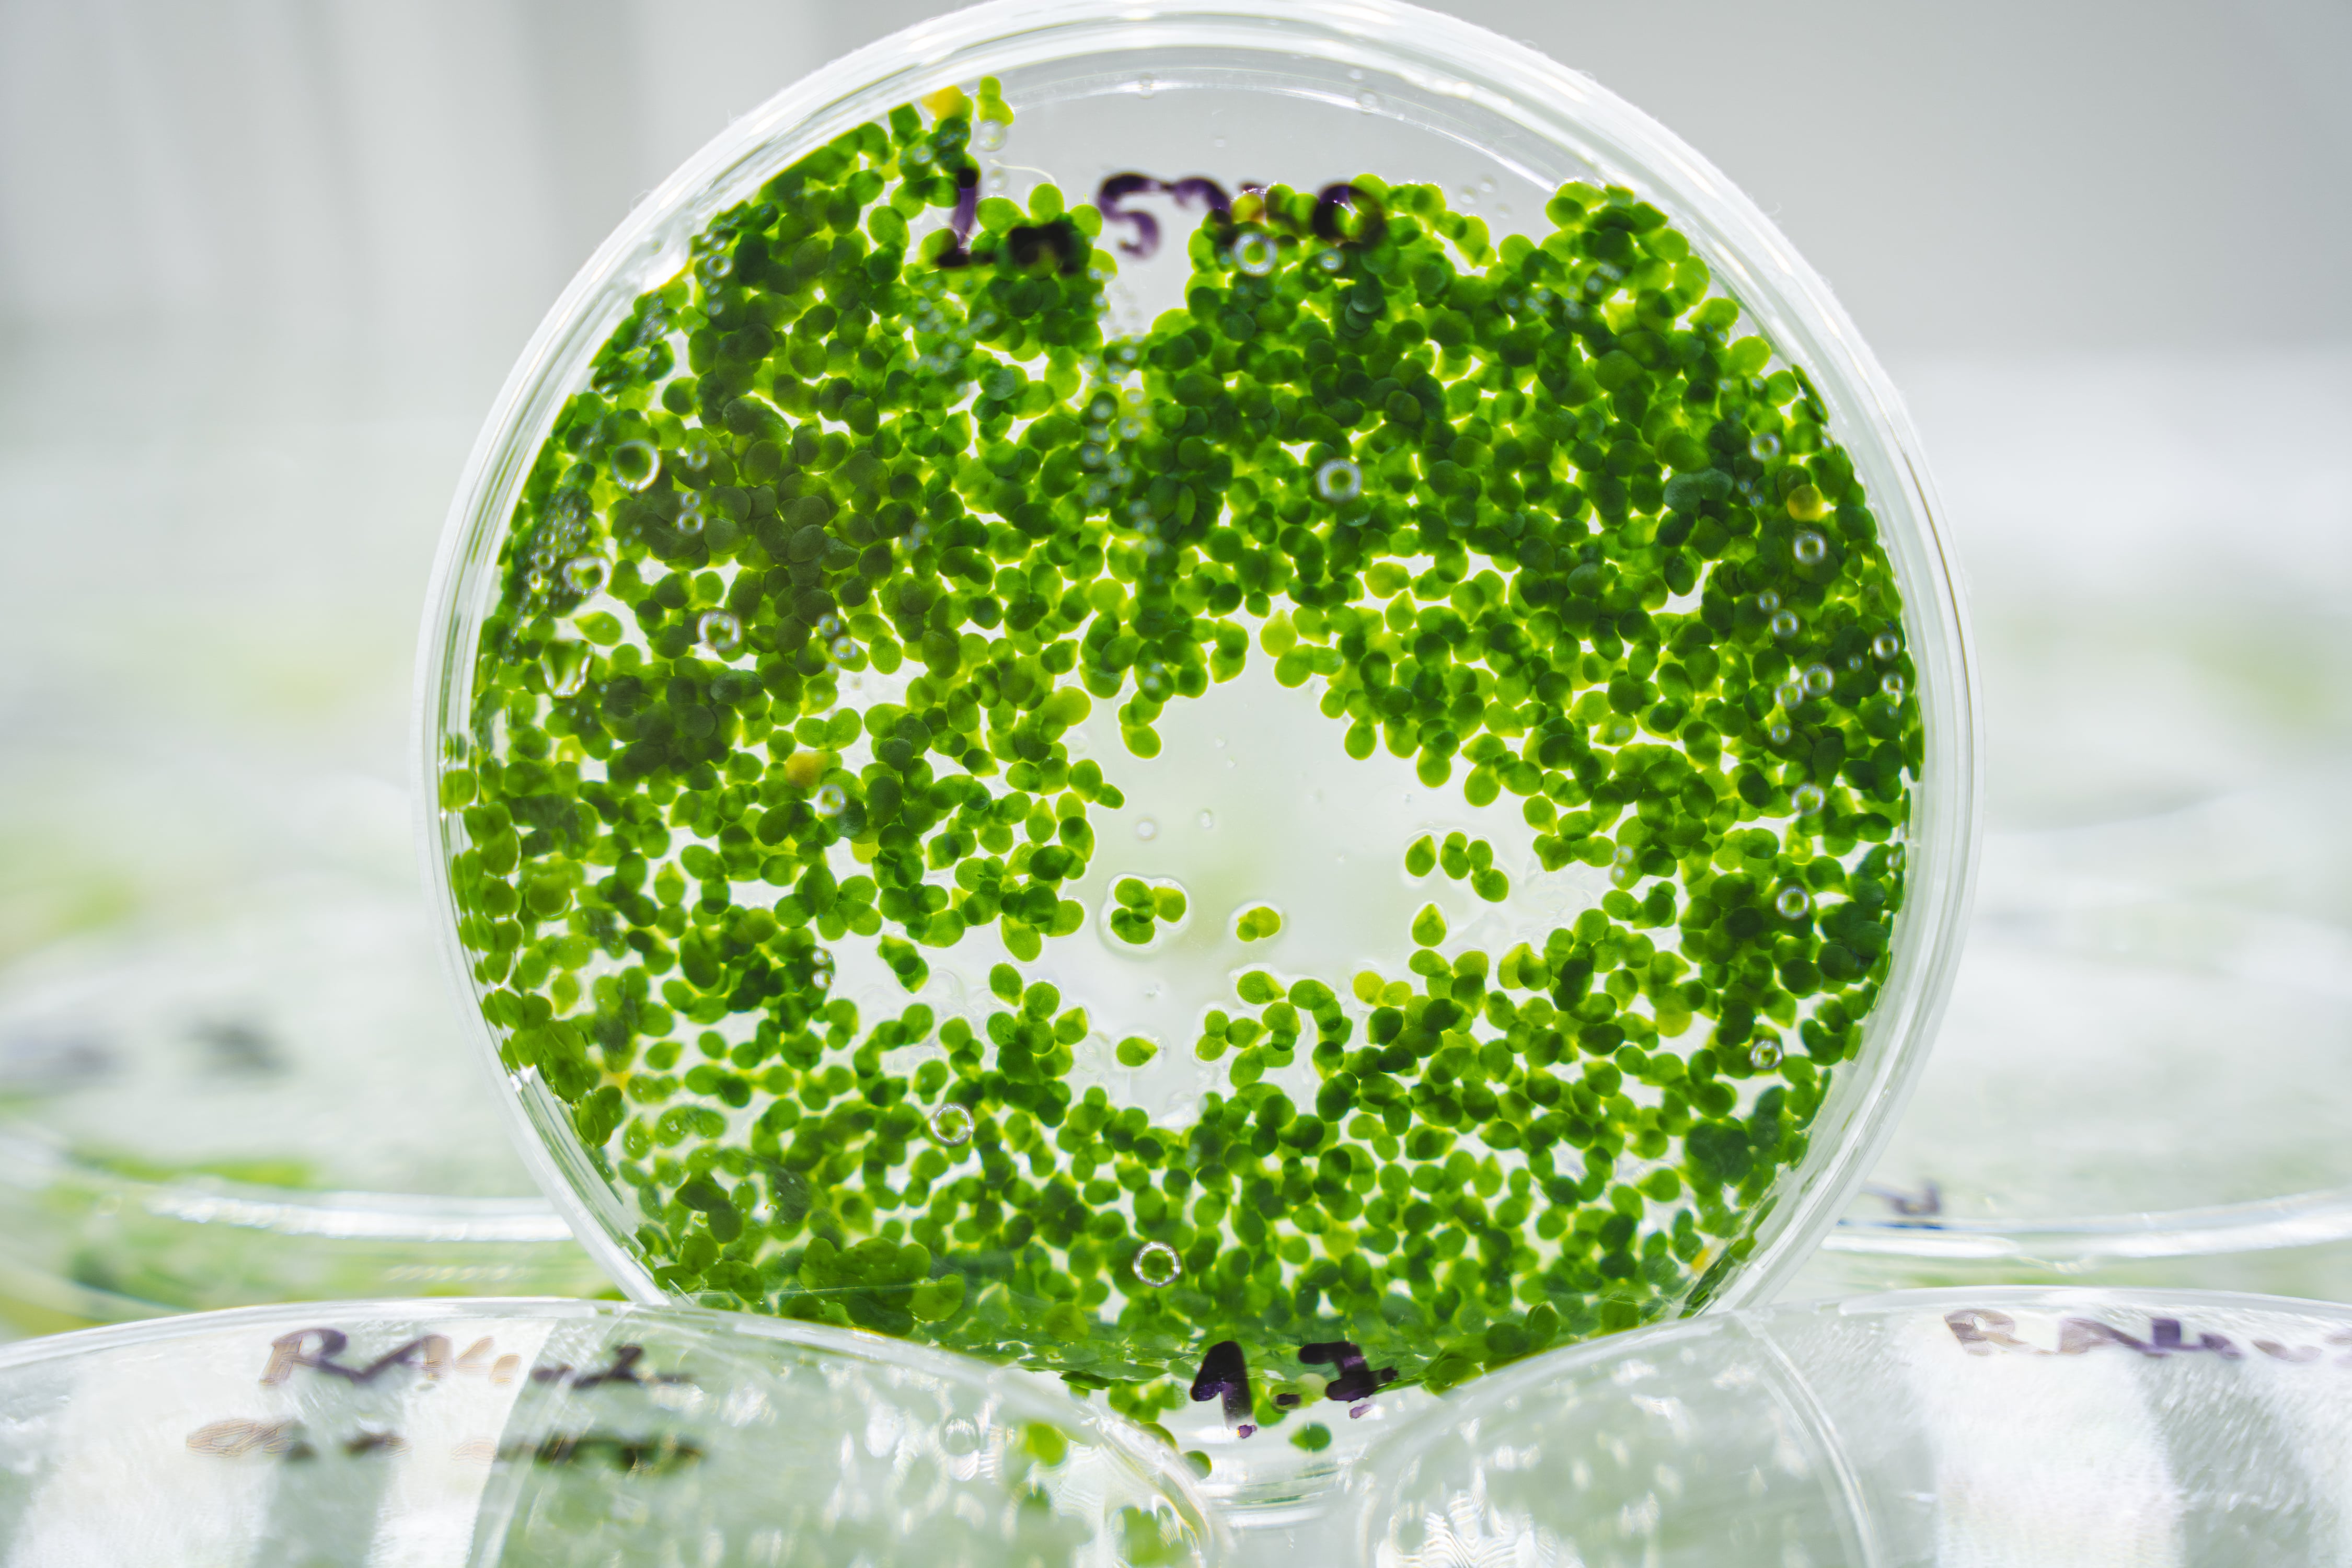

Rozhovory
Hostem podcastu P-LAB CAST byl Matej Zámečník, spoluzakladatel projektu iGEM Brno.
Tým studentů, zejména z prostředí MUNI a VUT v Brně se připravuje na účast v mezinárodní soutěži iGEM (International Genetically Engineered Machine), která se letos koná v Paříži. Projekt, s nímž tým iGEM Brno do soutěže vstupuje, se zaměřuje na produkci geneticky modifikovaného okřehku (duckweed). Pomocí cílených genetických úprav tým do genomu okřehku pomocí transpozonú zavedl geny, které umožňují zvýšit kapacitu rostliny pro asimilaci amoniaku a tím významně urychlit růst biomasy. Výsledná modifikovaná linie vykazuje až jedenáctinásobně vyšší produkci biomasy v porovnání se sójou – běžně využívaným zdrojem rostlinných proteinů. Projekt tak má potenciál nabídnout alternativní, rychle obnovitelný zdroj bílkovin pro potravinářské i průmyslové využití. Poslechněte si rozhovor a poznáte kompletní cestu a příběh, který za týmem stojí.
Odkaz na konkrétní díl podcastu - rozhovor s Matejem Zámečníkem v plné verzi – naleznete ZDARMA:
První díl podcastu P-LAB CAST Nejen o životě v laboratoři nás zavedl do Brna na Masarykovu univerzitu, kde nás přivítal Mgr. Matej Zámečník, spoluzakladatel projektu a týmu iGEM Brno. V zajímavém rozhovoru (jehož kompletní znění si můžete zdarma poslechnout na YouTube nebo Spotify) odpovídal na otázky, které se týkaly budování týmu pro studentský vědecký projekt spojený s vývojem duckweedu (okřehek, žabinec) a metodou jeho genetických úprav, která má pomoci farmářům nahradit sóju jako zdroj proteinu a globálně přispívat k ochraně životního prostředí.
Řeč byla také o přípravě na prestižní soutěž iGEM Grand Jamboree a způsobech, jak v ní potenciálně zvítězit, protože pro vítězství si tým iGEM Brno do Paříže jede! Bavili jsme se o tom, jak se geneticky modifikuje (programuje) nejrychlejší rostlina světa, o stovkách hodin v laboratoři (nejen při centrifugování), tisících e-mailech, ale i výsledcích a rozdílných způsobech financování aktivit. Zajímalo nás, jak náš host vnímá doktorské studium, povinné předměty na škole, nebo co se svým týmem očekával od náročné crowdfundingové kampaně na financování cesty a projektu.
Matej Zámečník dokončil své bakalářské studium molekulární biologie v Bratislavě, následně se přesunul do Brna a stal se magisterským absolventem oboru experimentální biologie rostlin na Přírodovědecké fakultě MUNI. Důvodem přesunu z Bratislavy do Brna byla zejména kvalitní laboratorní infrastruktura na brněnském campusu a v CEITECu, kterou považuje za špičkovou i na evropské úrovni. Vyzdvihuje i samotnou lokalitu brněnské univerzity: „Je to tu skvělé, protože na jednom kilometru čtverečním máte vše, co potřebujete: od laboratoří, přednáškových místností, spolužáků a špičkových vědců až po obchody.“
„To bylo poměrně zajímavé,“ začíná odpověď na první otázku, týkající se samotného projektu. Spoluzakladatel iGEM Brno poté vypráví o své cestě místní univerzitou, o budování týmu a o tom, jak se seznámil s ostatními zakládajícími členy (Matúšom Griešom a Miroslavom Rosputinským) a myšlence, kterou začala roční vědecká jízda za účastí na pařížském finále soutěže iGEM Grand Jamboree 2025. „Poprvé jsme se potkali v březnu 2024 a tým jsme postavili v říjnu během měsíce. Připravili jsme na univerzitě velkou náborovou kampaň a z 42 lidí vybrali 18,“ dodal. Tým je přitom oborově velmi různorodý nejen v oblasti biologie, zástupce zde má IT, technici z VUT pracující na hardwaru, má i svého ekonoma nebo stále ještě gymnaziální studentku s velkým talentem, Annu Podmanickou.
V podcastu Matěj Zámečník děkuje za pomoc mnoha lidem z vědecké obce, ale i konkrétně brněnským univerzitám MUNI a VUT. Jmenovitě pak vyzdvihnul přínos prof. Mgr. Tomáše Kašparovského, Ph.D., děkana Přírodovědecké fakulty MUNI a předsedy Rady vysokých škol. Tuzemští vědci a vyučující však nebyli jediní, u kterých tým hledal pomoc. V případě nejasností a slepých uliček se neváhal obrátit na světové lídry v oborech: „My jsme zvolili takovou strategii, že když narazíme na nějaký problém, napíšeme nejlepšímu člověku v oboru na světě, jestli by nám s jeho vyřešením nepomohl.“

Tým iGEM Brno komunikoval se špičkami světové vědy přes e-maily nebo LinkedIn. Využili i síť svých kontaktů nasbíraných během účastí na nejrůznějších veletrzích a konferencích.
Během své cesty tým od první poloviny roku 2024 několikrát změnil svůj původní záměr a koncept, kam s vývojem míří. „Původně jsme duckweed chtěli programovat tak, aby dokázal žít na močůvce, která obsahuje toxický amoniak a ten přeměnit na proteinovou biomasu přímo na farmě. Vymysleli jsme vědecký koncept modifikace a koncept autonomního vertikálního kultivátoru, po 3 měsících jsme jej chtěli ověřit. Ozvali jsme se jednomu z nejlepších rostlinných syntetických biologů světa, profesoru Hansonovi, který nám vysvětlil, že je zde velmi malá pravděpodobnost realizace,“ mluví o začátcích výzkumu Matěj Zámečník, a zároveň v podcastu detailně popisuje komplexní technické řešení, vědecké postupy a další změny, strategii vývoje záměrů až po závěrečnou část, která představuje metodu rychlé a efektivní genetické modifikace okřehku, nejrychleji rostoucí rostliny: „Když to celé dokončíme, my uděláme svůj nitroduckweed a pomůžeme tím naším farmářům a brazilským tropickým savanám. A vědci nebo společnosti napříč světem budou moci rychle a efektivně modifikovat okřehek taky, přispejeme tím k tomu, že se z něj stane biotechnologicky významná rostlina nebo plodina!“
„A naše iGEM story? Děláme »duckweed programmable and predictable« pro celý biotech svět, abychom pomohli farmářům a dokázali jsme s tím dělat další věci. Navíc to, že jim pomůžeme, splňuje další z podmínek soutěže »contribution to community«. Je to odemykání nového modelového organismu, a to je poměrně zajímavá věc,“ doplňuje spoluzakladatel projektu iGEM Brno a postupně se dostává k tématu soutěže, která je milníkem ve výzkumu skupiny.
iGEM Grand Jamboree, které vyvrcholí na konci října v Paříži, je považováno za biotechnologickou olympiádu a brněnská skupina nepodceňuje tedy ani důkladnou přípravu. Matej Zámečník se svými kolegy bude totiž na akci prezentovat výsledky a výzkum před 5 000 lidmi, skupinou porotců, investorů a odborníků v oblasti biotechnologií. A to vše v konkurenci 400 týmů z nejprestižnějších vysokých škol celého světa.
Ještě před samotnou cestou museli brněnští zástupci vytvořit svou wiki (webovou stránku) obsahující kompletní informace o projektu, postup výzkumu, validaci myšlenek na trhu a praktickým využitím. „My máme už nyní splněno několik věcí. »Multidisciplinaritu« splňujeme velmi, problém jsme validovali s okolním světem, a s tím souvisí kategorie pro organizátora důležitá – human practises, které máme za nás připraveny dokonale. Na našich stránkách, které v tomto patří k největším v soutěži, máme 142 lidí, se kterými jsme se o tom bavili a jejich feedback velmi často zapracovali do našeho postupu. Sice to asi nikdo nepřečte, byla hrůza to psát, ale máme to.“ (smích)
„Bavili jsme se s vítěznými týmy z posledních let. (smích) A víme přesně, co musíme udělat pro to, abychom zvýšili šanci na vítězství,“ komentuje Matej Zámečník a dodává, že toho nebude málo posléze ani na místě, pokud chtějí mířit na příčky nejvyšší: „Vzhledem k rozdělení našeho projektu na 3 subtýmy (21 lidí) a komplexnosti projektu, je nejdůležitější, aby všichni nyní dostali kompletní podrobné informace o tom, co se všechno udělalo a celý příběh. Na našem stánku musí stále někdo být, a musí být připraven nás reprezentovat a prezentovat projekt. Další lidé přitom budou chodit v Paříži po Jamboree a říkat tam, jak jsou duckweed a iGEM Brno úžasné a co všechno jsme udělali. A to je důležité pro možný úspěch.“
Tým iGEM Brno očekává, že by se na finálové akci měl umístit v TOP 10, o dalším posunu vzhůru mohou rozhodovat detaily a lepšímu pořadí může přispět třeba také vyšperkovaná prezentace, ale i fakt, že si tým do Paříže přiveze svůj kultivátor, autonomní systém o rozměrech 2 x 1,5 m: „Je to naše velká výhoda, protože máme něco, co je fyzické, je to vidět, vypadá high-tech a může zaujmout. Vidíte svítící kultivátor, hromadu světýlek, trubek, kabelů, stříká voda, svítí to... A lidi jsou z toho opravdu unesení. Je to funkční, je to super, a navíc je to esteticky dobré, takže to dodá dojem navíc. Je sice organizačně náročné vše zařídit a přinést, ale věříme, že to pomůže.“
Jak získávat financování na takový projekt? Tým iGEM Brno na svůj výzkum a cestu do Paříže na finále soutěže zvolil několik směrů: „Financování pocházelo ze 3 zdrojů a my jsme šli postupně tak, jak náročné bylo prostředky získat. První byly univerzity, což byla asi polovina rozpočtu, kterou nám pomohly zafinancovat. Další část jsme řešili u soukromých firem a nadačních fondů. Já mám rád, když vás podporuje někdo, kdo si ty peníze opravdu vydělal a chce vás takto podpořit. A pro poslední část financí, která nám chyběla, protože jsme to rozběhli příliš, jsme se obrátili na lidi prostřednictvím crowdfunding platformy.“
iGEM Brno v rámci kampaně Mendel 2.0 vybral za první 3 dny 225 000 korun a celkově 336 500 korun. „My jsme vůbec nečekali, že to tak rychle vysbíráme,“ dodává Matej Zámečník a zároveň vysvětluje důvod odkazování na Mendela: „Já ho uznávám, a i my stavíme na tom, co on popsal. Ale přišlo mi fajn udělat projekt Mendel 2.0 a i to naše sdružení se jmenuje Generation Mendel a crowdfunding byl Mendel 2.0. Stavíme na základech, ale posouváme to do moderního a světa. Když se totiž v biotech světě zeptáte, co je Brno, tak nikdo netuší, ale když se zeptáte na Mendela, vědí všichni. A my bychom byli rádi, kdyby bylo Česko a Slovensko známé i něčím jiným než Mendel.“
Tým čeká soutěž iGEM Grand Jamboree už v závěru října! Držíme palce a věříme, že se do Česka a na Slovensko vrátí s vítězstvím.
P-LAB CAST Nejen o životě v laboratoře naleznete na YouTube a v podcastových aplikacích:

Autor: Vojtěch Pres, Lucie Kuchtová
Zdroj úvodní fotografie: archiv iGEM Brno - Marie Štefková


